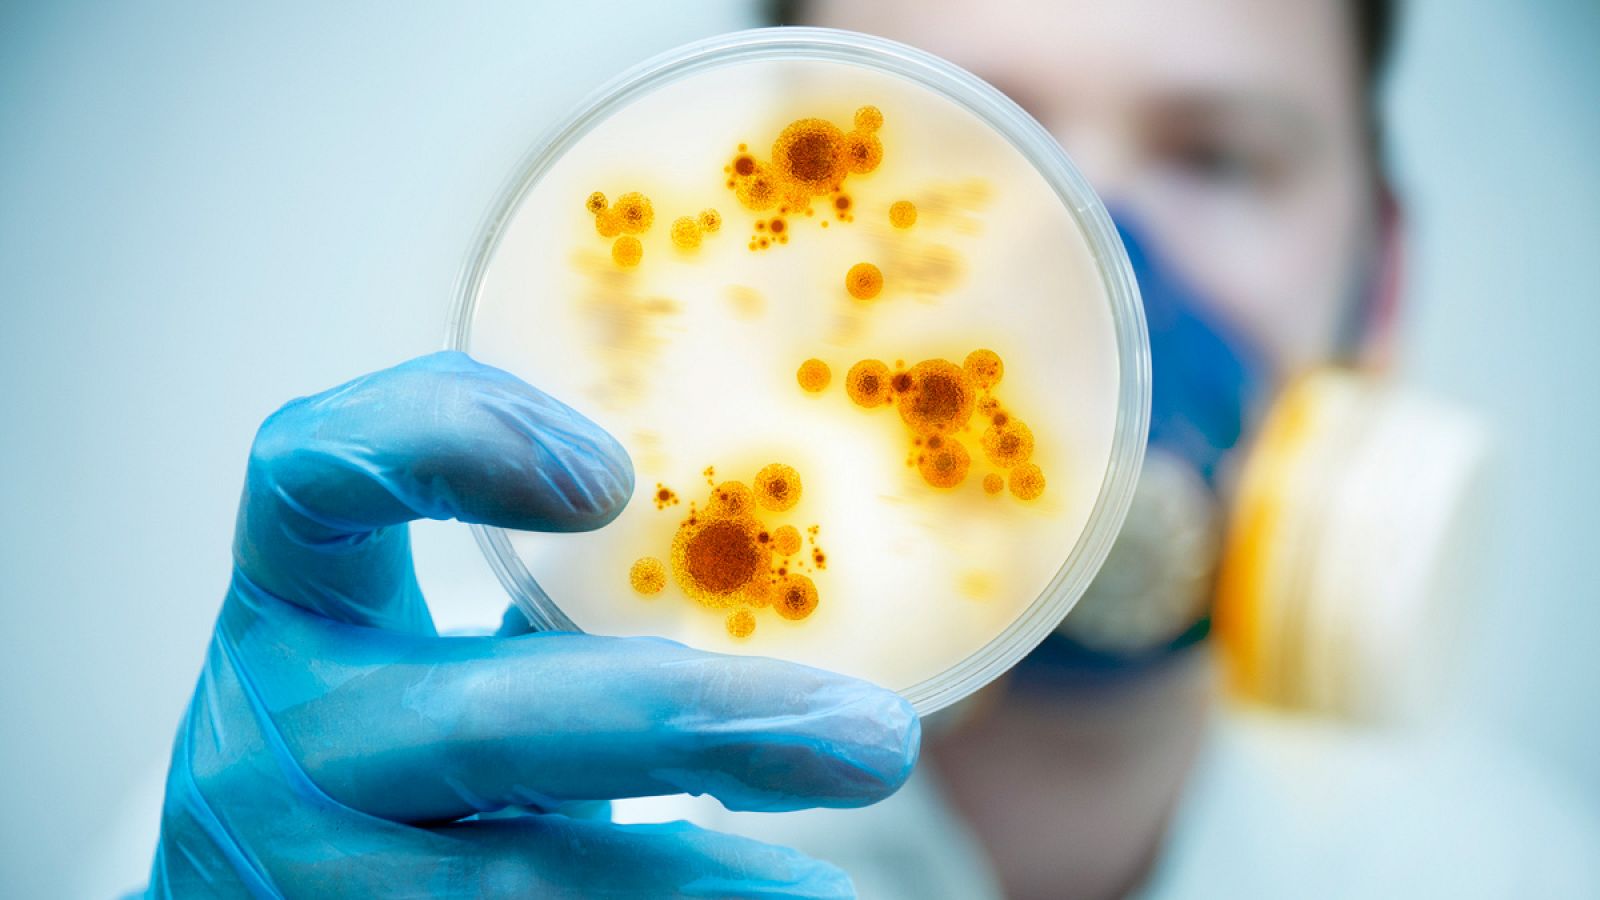
En la última década, se ha producido un incremento del 40% en el consumo de antibióticos en humanos.

Las superbacterias provocarán 10 millones de muertes al año en 2050
- En la actualidad, causan anualmente la muerte de 26.000 europeos
- Son datos de la Asociación para el Descubrimiento de Nuevos Antibióticos
- Los expertos inciden en la necesidad de usar los antibióticos con responsabilidad

La Asociación para el Descubrimiento de Nuevos Antibióticos en España (AD-ES) ha advertido de que 26.000 personas mueren en Europa cada año por bacterias resistentes a los antibióticos que, además, provocan infecciones graves a cuatro millones. España se sitúa a la cabeza de la UE en consumo de estos fármacos.
Ante esta situación, la AD-ES subraya que las superbacterias resistentes a los antibióticos constituyen una amenaza global. De hecho, los expertos estiman que si no se toman medidas urgentes, en el año 2050 estos microorganismos provocarán 10 millones de muertes al año en todo el mundo.
Esta asociación quiere incidir en la necesidad de educar a la población en el uso responsable de estos fármacos y también de mantener el compromiso con la investigación de nuevos tratamientos para combatir las bacterias multirresistentes.
El doctor Domingo Gargallo-Viola, presidente de AD-ES, que además colabora con la Agencia Española de Medicamentos y Productos Sanitarios, dependiente del Ministerio de Sanidad, recuerda que en la última década el problema se ha agravado de forma considerable, dado que "se ha producido un incremento del 40% en el consumo de antibióticos en humanos y posiblemente mucho mayor en producción animal".
“España está a la cabeza de la UE en el consumo de antibióticos. “
Según el último Eurobarómetro, el 47% de los españoles ha consumido antibióticos en el último año, lo cual sitúa a España a la cabeza de la UE, sólo por detrás de Malta. Este porcentaje es más del doble del registrado en Suecia o en Holanda (18-20%).
Desconocimiento general
Pero lo más grave, a juicio del doctor Gargallo, es que "un importante porcentaje de los consumidores no sabe realmente para qué sirven los antibióticos. De hecho, casi la mitad de los españoles cree que los antibióticos son efectivos contra los virus, lo cual no es cierto". En este contexto, considera "urgente actuar, de forma coordinada, incluyendo los gobiernos, las instituciones sanitarias (hospitales), universidades y la industria para luchar contra esta amenaza".
El doctor Gargallo, que participará en la Jornada sobre el Uso Prudente de los Antibióticos que tendrá lugar este viernes en el Ministerio de Sanidad, señaló que los esfuerzos "siempre tienen que realizarse de forma global y coordinada" con los 28 países de la Unión Europea y a nivel mundial para "concienciar a la población sobre la necesidad de racionalizar el consumo de antibióticos".



